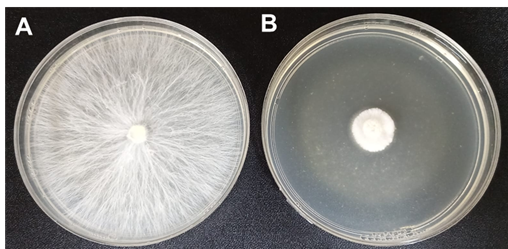

eISSN: 2576-4462


Research Article Volume 6 Issue 4
1Departamento de Parasitología, Universidad Autónoma Agraria Antonio Narro. Calzada Antonio Narro 1923, Buenavista, C. P. 25315, Saltillo, Coahuila, Mexico
2Universidad Michoacana de San Nicolás de Hidalgo, Laboratorio de Microbiología Ambiental, Instituto de Investigaciones en Química y Biología. Avenida Francisco J Mujica S/N. Colonia Felicitas del Rio, C. P. 58000, Morelia, Michoacán, México
3Campo Experimental Saltillo-INIFAP. Carretera SaltilloZacatecas, km 342+119, Núm. 9515, Buenavista, Saltillo, Coahuila. C. P. 25315, Mexico
Correspondence: Jiménez-Pérez O, Departamento de Parasitología, Universidad Autónoma Agraria Antonio Narro. Calzada Antonio Narro 1923, Buenavista, C. P. 25315, Saltillo,Coahuila, Mexico
Received: September 05, 2022 | Published: September 26, 2022
Citation: Gallegos-Morales G, Sánchez-Yáñez JM, Hernández-Castillo FD, et al. Chitosan in the protection of agricultural crops against phytopathogens agents. Horticult Int J. 2022;6(4):168-175. DOI: 10.15406/hij.2022.06.00261
Mexico is considered one of the main vegetable producing countries, however, its production is affected by several phytopathogens, whose control of these pathogens is based on the use of agrochemicals, which cause consequent environmental and health damages. In 2018, Mexico ranked 5th in the world in the consumption of fungicides and bactericides in agriculture. For this reason, new alternatives to control phytopathogens are important, with natural compounds with antifungal properties such as chitosan, a biopolymer of N-acetyl-D-glucosamine and D-glucosamine units linked by β-(1-4) bonds derived from the deacetylation of chitin with alkalysis (NaOH) or enzymatic hydrolysis. Chitosan is extracted from exoskeletons of arthropods. Research shows that it inhibits the growth of phytopathogens, due to its polycationic nature depending on molecular weight and deacetylation percentage. With other antifungal properties, they are inducer of phytoalexins, promotion of plant growth and biostimulant of beneficial microorganisms, due to its useful and economic potential agricultural application in technological innovation.
Keywords: plant health, natural inhibitor, phytopathogens control
Agriculture in Mexico ranks 11th in the world in the production of agricultural crops, with an area of 20.7 million Ha with 262.5 tons, with profits of 675 billion pesos, it is the seventh largest food exporter in the world among the vegetables that export the most avocado, berries, tomato, and pepper.1 Severely attacked pests and diseases by fungi, bacteria, nematodes, viruses, insects, among others.2 The main problem is the fungal genera of phytopathogens; Fusarium sp., Alternaria sp., Penicillium sp., mildew, rusts, and oomycetes such as Phytophthora.3 These phytopathogens cause damage individually or together with great losses in production,4 such as: Rhizoctonia solani, Sclerotium rolfsii, Verticillium, Phytophthora capsici, Pythium spp., and Fusarium spp., responsible for the pepper wilt, with losses of up to 90%.4,5
The main control method of these phytopathogens are chemical fungicides.6,7 In 2018, Mexico ranked 5th in the world in the consumption of fungicides and bactericides with a total of 28,601 tons, followed by insecticides and herbicides.2 Such as Metam sodium,5,8 2Thiocyano methyl thiobenzo thiasol, Metalaxil, Tebuconzole, Carbendazim, Azoxystrobin, Propamocarb, as examples.8
The application of these chemicals causes damage to human health, environmental pollution,9,10 increased production costs, imbalance in soil biodiversity, inhibit or kill the beneficial microorganisms9 and induction resistances to phytopathogens for these fungicides.11
Environmentally, other control methods are of value, in harmony with agroecosystems, soil biodiversity and human health without resistance in phytopathogens. Research indicates that one of the best alternatives to control phytopathogens is with antagonistic microorganisms,6,9,11 botanical extracts12 and others with antifungal properties such as chitosan12-14 with results positive in the natural control of phytopathogens.
Chitosan is a product of the deacetylation of chitin, widely distributed in nature, in shells of crustaceans, insects,7,15-19 in nematodes, cephalopod beaks20 and in fungal cell walls.7,15,19
Chitin is a nitrogenous polysaccharide, with a high molecular mass21 consisting of poly-β-(1,4)-N-acetyl-D-glucosamine (GlcNAc),15-25 covalently bound to proteins and catechol’s.15 It is the second most abundant biopolymer in nature after cellulose.15-26 It forms crystalline microfibrils, structural components of arthropod exoskeletons or fungal cell walls.18,26 Chitin was described in 1811, by Henri Braconnot who isolated it called fungina, from higher fungi, in 1823 Odier called it chitine.24
In the soil, chitin is degraded to GlcNAc monomers by microorganisms that synthesize chitinases and N-acetylglucosaminidases with chitosan release by deacetylases.20
Chitosan was described in 1859 by Rouget.27 Due to the deacetylation of chitin to a percentage greater than 50%.18 It is a high molecular weight linear polycationic heteropolysaccharide biopolymer,27 with copolymers of N-acetyl-D-glucosamine and D-glucosamine linked by β-(1-4) glycosidic bonds,7,18,27-30 Chitosan is soluble in acidic pH15,18 due to the protonated free amino groups,21,26 unlike chitin only soluble in concentrated acids, fluoroalcohols,21 in dimethylacetamide or N-methylpyrrolidone26 with a concentration of lithium chloride at 5-7%.21,26
Figure 1 Shows chitosan dissolved in water acidified with acetic acid. Chitosan is soluble in acidic pH.15

Figure 1 Solubility of chitosan in water acidified to pH 5.5 with acetic acid. A) chitosan powder. B) diluted chitosan, viscous consistency.
Due to the amino group, biocompatible and biodegradable, chitosan has value in health, industry, biotechnology and agriculture15,26-32 has the property of inhibiting the growth of phytopathogens, without risk of environmental contamination, and harmless to human health. It is an alternative to reduce or avoid the use of chemical pesticides.15,26,27,33 Research on the toxicity of chitosan indicates that it has an oral LD50 in mice at 16 g/day per kg of body weight, higher than that of sucrose.27
The inhibition of the growth of phytopathogens depends on the low molecular weight, with a high degree of deacetylation at acidic pH, with a positive charge due to the deprotonated amino groups.34
Chitosan extraction is by degradation of shrimp exoskeletons.17,23,35 Mexico, one of the main shrimp producers, is the seventh in the world with 237, 647.00 tons, in 2019; Sinaloa was the maximum with 96,000.00 tons, followed by Sonora with 75,000.00 tons and Nayarit with 17,000.00 tons.36 48-60% of this production represents the weight of discarded exoskeletons that generate slowly decomposing waste, which causes environmental pollution. However, shrimp waste is a raw material in the extraction of chitin and chitosan because it contains between 15-20% chitin, in addition to proteins, lipids, pigments and minerals.37 Chitosan has phytopathogen growth inhibition activity, induces plant immunity to fungal diseases,20,27 provides nutrients such as ammonium or nitrogeno and calcium.20 Therefore, the exploitation of these residues avoids environmental pollution.
To obtain chitosan from chitin, extraction with alkalis or strong acids is initiated, which has some drawbacks such as inconsistency in chemical and physical properties that cause environmental pollution. Other alternatives are bacterial fermentation,38 by chitinases21 in lactic acid fermentation.22,26 These methods separate chitin from other constituents such as: demineralization, deproteinization and depigmentation.21,38 Chitosan is subsequently extracted by deacetylation of chitin, with NaOH.15,27-30 Others involve the enzyme chitin deacetylase30 hydrolyzes N-acetamido bonds of chitin to convert it to chitosan, chitin deacetylase is synthesized by genera and species of fungi and bacteria such as: Bacillus sp., and Serratia sp.,39 Another method by microwave irradiation and ultrasound.24 Deacetylation removes the acetyl groups from the chitin chain until reaching the amino group (NH2).30 Figure 2 shows where the acetyl group of chitin is deacetylated to an amino group to form chitosan.

Figure 2 Difference in the structure of chitin and chitosan. Source: Curbelo et al.,30
Chemical method: consists of the following steps; first, the exoskeletons of the arthropod are washed, dried and crushed to demineralize them with 0.6 N hydrochloric acid (HCl) in a 1:11 solid-liquid ratio for 3h at 30°C. The following is deproteinization with 1% NaOH for 24h under constant stirring at 28°C, in each step the washed solution is filtered to remove the alkali, thus obtaining chitin35,40 is deacetylated to obtain chitosan with 50% NaOH in a 1:4 solid-liquid ratio, under constant stirring for 2 h at 60°C, then 2 h at 100°C,35,40 other authors report deacetylation due to different alkali concentration and time as reported by Sedaghat etal.,41 with 50% NaOH in ratio 1:8 solid-liquid at 100°C stirring for 10h, the product is filtered and washed with sterile distilled water to obtain neutral pH and remove residues.30,40 The effectiveness of deacetylation depends on the NaOH concentration, the solid-liquid ratio, the temperature and the reaction time.30
Bacterial fermentation: consists of genera and species of bacteria that synthesize quitinasas,38,41,42 Bacillus spp.,38 Lactobacillus,42 Pseudomonas aeruginosa, Serratia marcescens,41 for a fermentation enriched with sucrose and shrimp shells for 7 days under constant agitation at 100rpm, after fermentation filtering to separate chitin of the liquid.38,41 Rosmawati et al.,42 report that bacterial fermentation achieves a higher yield and degree of acetylation compared to the chemical method. Chitin is subsequently subjected to deacetylation for chitosan, with NaOH.38,41
Lactic acid fermentation (LAF): consists of the use of whey, with specifics genera of lactic acid bacteria: Lactobacillus sp. enriched with sugars to obtain energy, lactic acid is generated that solubilizes minerals and proteins the exoskeletons by activating proteolytic enzymes. In an anaerobic bioreactor22,43 whey, sugar and the crushed exoskeletons of the arthropod are placed, at a ratio of 1:2 solid-liquid, for a week or more, with periodic agitation of 6 hours,26 then the solid is separated, washed and dried, chitin is obtained.22,43 This method has advantages over the chemical method, it does not pollute by not using corrosive chemicals,22 chitin easily recovers lactic acid and is used for another purpose,22,23 it is of low production cost allows to extract calcium, pigments and proteins of commercial value,22,23 the disadvantage is the extraction time the chitin, from one week23 to three weeks.22 To obtain chitosan, a deacetylation of chitin with NaOH is required.23,26
Enzymatic method: Cisneros et al.,24 extracted chitin from shrimp exoskeleton, first by demineralizing it with glacial-grade acetic acid under agitation, then fractions of the exoskeleton were vacuum filtered, then deproteinized with α-chymotrypsin and papain. Subsequently, the exoskeleton fraction was depigmented with 97% ethanol under continuous agitation and washed with sterile distilled water for 12 hours, to obtain chitin. Urbina-Salazar et al.,25 extracted chitin from Agaricus bisporus flour at 10% suspended in water with a protease (alkalase), the hydrolysate was adjusted to pH 8.5, centrifuged at 10,000 x g, at 4°C for 15 min, the precipitate is washed with running water and resuspended in one liter of water, sterilized in an autoclave at 121°C for 20 min, and centrifuged for 15 min at 10,000 x g to separate the chitin from the liquid. The advantage compared to the chemical method is less contamination, higher production cost compared to the FAL method, less control of the variables during the extraction and.24 As in the previous methods, it requires deacetylation of chitin with 50% NaOH to obtain chitosan.24,25
These methods have advantages over the chemical method, since the reagents cause environmental contamination with a lower quality chitosan, although these methods reduce environmental contamination by using fewer chemical reagents and better-quality chitin and chitosan. However, it has some disadvantages such as the production time of chitosan longer than the chemical method.
In agriculture, chitosan is useful for various uses: it improves germination, increases the radical uptake of microelements, increases the yield of a wide variety of agricultural crops, facilitates the formation of plant physical barriers to give resistance to pests and diseases,35 has an antagonistic effect against numerous phytopathogenic agents such as; Fusarium spp., Rhizoctonia solani,14 Alternaría spp,28,32,44 Colletotrichum sp.,28 includes oomycetes,45 and genera and species of phytopathogens of bacteria and nematodes,46 induces defense mechanisms in plants.28,35,46 In addition, chitosan is a bio- stimulant of growth-promoting microorganisms of the type: Trichoderma spp.,29 such as genera and species of mycorrhizal fungi47 of actinomycetes: Streptomyces, Kitasatospora, since they synthesize chitosanases that hydrolyze chitosan to use it as a carbon and nitrogen source.48 While chitosan is compatible with other plant products such as botanical extracts12 and carbon nanoparticles,49 with antagonistic activity.
Control of phytopathogens
Research shows the antimicrobial effect of chitosan against fungi, oomycetes and phytopathogenic bacteria.45 In that sense Xoca-Orozco et al.,28 enriched medium and low molecular weight chitosan in vitro inhibited 90% of mycelial growth, sporulation, and germination of 2 strains of Colletotrichum sp, as well as the incidence and severity in fruits avocado with chitosan films. While Mohammed et al.,50 inhibited the in vitro growth of Rhizoctonia solani in a culture medium with 1% chitosan. Hernández et al.,51 report a decrease in the damage caused by R. solani in beans with chitosan, compared to using it and the chemical control (TMTD 80%). Ramírez-Benítez et al.,52 applied chitosan in vitro at concentrations of: 0.4, 0.8, 1.6, 2.4, 3.2 and 4mg/L which inhibited mycelial growth of P. capsici from 88% to 100%, the inhibition improving as the concentration of chitosan increased. Rodríguez-Pedroso et al.,53 reported in vitro that a higher chitosan concentration of 4g/L found better inhibition of mycelial growth of Bipolaris oryzae (97.2%). Other studies show the fungicidal effect of chitosan so by; Hernández et al.,54 for the control of Sclerotium rolfsii in beans, Ramos-Guerrero et al.,55 control of Colletotrichum gloeosporioides and Rhizopusstolonifer in soursop, González-Estrada et al.,56 control of Penicillium citrinum in garlic, López et al.,57 control of Alternaría solani in tomato. Figure 3 shows what was mentioned above, where in a Petri dish treatment with PDA culture medium supplemented with chitosan at 200 ppm, it was possible to inhibit the in vitro mycelial growth of Sclerotium rolfsii.
Figure 3 In vitro mycelial growth inhibition of Sclerotium rolfsii by adding chitosan to potato dextrose agar (PDA) A) Control, S. rolfsii grows on PDA at 72 h. B) Growth of S. rolfsii in PDA with chitosan at 72 h.
The factors that influence the inhibition of a phytopathogenic agent are the concentration, the percentage of deacetylation and the molecular weight of chitosan,27,28 authors report that with less weight molecular and a higher percentage of deacetylation chitosan has a greater antifungal action.58
The mechanisms of action of chitosan against fungi and bacteria are diverse: changes in the permeability of cell membranes, due to polycationic interaction28,58 chitosan contains a high amount of positive charges, one charge for each glucosamine residue57 of the amino group of chitosan that bind with the negative charges of the surface of the cell membrane of the phytopathogen,28,58 cause loss of liquids from the cytoplasm,53 malformations and cellular disorganization,28,53 which could be key in the antifungal action given that most of the genera and species of phytopathogenic fungi have a negative charge in the cell wall.58 It forms spaces in the cell wall to enter and reach the cytosol, in addition to the changes induced in the permeability of the plasma membrane, it alters the main function of nutrient entry and waste excretion.28,59 It also chelates metals, which inhibits the growth of these phytopathogenic agents.58 Chitosan causes an imbalance of K+ and Ca2+ ions in the cell membrane, causing the release of small molecules: phosphates, nucleotides and enzyme substrates of respiration, fungal differentiation, and sporulation12 inhibits ATPase activity.28 It is reported that chitosan interferes with the transformation of DNA into RNA, prevents cell growth, as well as the synthesis of proteins linked to carbohydrates, affects the genetic regulation of chitin synthesis in the cell wall.28,52,60
In the microbial spores, it causes disorganization of the cytoplasm with loss of intracellular content, affects the spore membrane,52 due to the relationship of the amino groups of chitosan that interact with the negative charge of the cell membrane of the spore and inhibits germination12 In the mycelium, the loss of nutrients causes vacuolation, with the formation of thin, distorted, and malformed hyphae.53
In the genera and species of Gram negative (-) bacteria, chitosan is attracted by electrostatic attractions, with lipopolysaccharides of the outer membrane, and affects permeability. In Gram positive (+) bacteria, it affects the cell wall by binding to teichoic and lipoteichoic acids and inhibits the interaction between the cell wall and the cell membrane, with loss of important molecules, in addition, osmotic imbalance.13
There are several studies that demonstrate the inhibitory effect of chitosan against phytopathogenic bacteria as reported by Castañón-Viveros et al.,61 that in vitro inhibited Clavibacter michiganensis culture medium supplemented with added chitosan and oleic acid. Campo et al.,62 also inhibited Escherichia coli, Enterococcus faecalis, Staphylococcus aureus and Klebsiella pneumoniae in vitro using with chitosan and orange extract.
The chitosan together chitin used in the control of phytopathogenic fungi and bacteria also has a nematicideaction as Ladner et al.,63 that in potted tomato soil by adding chitin reduced the number of juveniles, eggs and galls caused by Meloidogyne incognita. Radwan et al.,46 report that when treating the soil planted with tomato in pots, chitin and chitosan had a nematicide against M. incognita, chitosan being the most effective in reducing the population of juveniles and galls in the root system of the tomato, although lower than the chemical treatment with oxamyl. Belair et al.,64 report the inhibition of M. hapla with the application of chitin-enriched Streptomyces lydicus, which decreased the number of juveniles and galls on tomato roots separately or only one of the two. García-Munguía et al.,65 report in vitro a 100% inhibition of Meloidogyne sp attack by adding chitosan. The nematocidal effect of chitin and chitosan have not been clearly explained, it is assumed that they stimulate the growth of nematophagous microorganisms that synthesize chitinases. In addition to the toxicity of chitin and chitosan on nematodes.46,63 In the soil there is a generation of ammonia due to the mineralization of chitin.46
Inducer of plant resistance mechanisms
The application of chitosan induces plant resistance to pests and diseases, by the synthesis of R proteins (RP) in response to pathogenesis of biological or abiotic origin16,66,67 such as endo and exochitinases, β-1,3-glucanases52,66-68 and peroxidases.33,66 It also increases the synthesis of secondary metabolites associated with defense against damage and plant diseases such as phytoalexins,16,68,69 catalases, polyphenoloxidases,70 flavonoid-type phenolics and terpenes.69,71
Chitosan stimulates the generation of phenylalanine ammonia-lyase, a fundamental enzyme to initiate the plant response against the attack of pathogens of the Fusarium sp type and other phytopathogens66,68,71 by increasing the synthesis of salicylic acid, better plant growth is induced.71 In addition, it regulates the levels of reactive oxygen species (ROS) related to oxidative stress that leads to cell aging and apoptosis in response to the negative action of environmental and biological factors against plant health.59 Chitosan increases the formation of callose, a sugar that is released when the plant suffers biological damage such as phytopathogens or mechanical damage,58 for the lignification of the cell wall,66-68 also, in the formation of papillae and tyloses that prevent endophytic phytopathogenic agents from penetrating the interior of the plant.58
Liao et al.,47 report that when plants detect chitin from the cell wall of phytopathogenic fungi, they induce the synthesis of chitinases that hydrolyze the fungal cell wall, with the release of chitooligosaccharides that induce the expression of plant defense genes, increases cytosolic calcium levels, the formation of ROS and callose.
Promotion of plant growth
It has been shown that the application of chitosan stimulates plant growth,57 for example, López-Corona et al., 35 demonstrated in Salicornia bigelovii a positive effect on the phenology response variables: length root, number of shoots and biomass: fresh and dry weight, compared with the response of S. bigelovii with indole butyric acid. Molina et al.,72 reported a greater root mass and vigor of rice seedlings when applying chitosan in the seeds compared to seeds without chitosan. The plant growth promoting effect of chitosan is because it improves the distribution of O2 (oxygen) in the roots. Chitosan confers resistance to stress due to lack or excess of water, due to changes in the cell membrane. Likewise, López et al.,57 obtained higher growth and production in tomatoes treated with chitosan at a concentration of 300mg/L compared to tomatoes without chitosan, because chitosan increases the chlorophyll content in the leaves. While Rivas-García et al.,73 in two tomato varieties increased yield. Reyes-Pérez et al.,68 with the application of chitosan at a dose of 2g/L-1 in two tomato varieties, increased the percentage of germination, growth and yield; because chitosan increases photosynthesis, chlorophyll synthesis induces stomatal closure for more efficient use of water, in addition, chitosan degradation generates ammonium, a source of plant nitrogen. There are other references to the stimulating action of chitosan in a wide variety of agricultural crops: such as Phaseolus vulgaris,74 in tobacco,75 in Oriza sativaor rice,72,76 cucumber,68 halophytic plants such as S. bigelovii,35 in Sorghum vulgare,,17, turnip77 and cocoa.68
There are antecedents on the compatibility of chitosan with genera and species of plant growth promoting microorganisms. N-acetyl-D-glucosamine compounds participate in the interaction between Rhizobium and legume roots; in nodulation factors (Nod) of Rhizobium,47 as well as acting as signalers for the formation of mycorrhization (Myc) of vesicular arbuscular mycorrhizal fungi. In this regard Rautela et al.,29 reported the compatibility of chitosan with Trichoderma asperellum,, to use it as a carbon and energy source with generation of enzymes for the degradation (cellulose and chitosanase) as well as other secondary metabolites(tetradecanoic acid, acid 1, 2-Benzenedicarboxylic), the enrichment of chitosan with T. asperellum improves the ability to control phytopathogens. The use of chitosan by Trichoderma species is due to the low fluidity of the membrane with a lower content of polyunsaturated acids or fatty acids of the linoleic acid type, since entomopathogenic fungi use chitosan as a source of carbon and energy. Escudero et al., report the compatibility of chitosan with Pochonia chlamydosporia, a parasitic fungus of phytoparasitic nematodes at maximum concentrations of 2 mg/mL-1. Chitosan is toxic to genera of phytopathogenic fungi as well as: Fusarium, Rhizoctonia and Verticillium at a concentration of 0.1 mg/mL-1 but the viability of chlamydospores. report the in vitro and in vivo compatibility of chitosan and Bradyrhizobiumjaponicum, the concentration of 10 mg/mL-1 of chitosan hydrolyzate was the one that induced the highest number of colony-forming units per mL-1 (CFU/mL-1) being higher than the control, while at a concentration of 500 mg/ mL-1 of chitosan and chitosan hydrolyzate the number of CFU was reduced, however, it was similar to the control, with respect to the invivo test in soybean plants the number of nodules was higher at concentrations of 100 and 500 mg/mL-1 of both presentations of chitosan foliar applied with respect to the control. The inhibitory effect is attributable to the type of chitosan and the concentration used, having as reference the minimum inhibitory concentrations of 0.01 to 1%. Like Agbodjato et al., report that through the combined application of chitosan and lant growth promoting bacteria as: well as: Azospirillum lipoferum, Pseudomonas fluorescens and P. putida inoculated in Z. mays seeds, they obtained an increase in some parameters such as germination, shoot weight, greater height, number of leaves, biomass and higher N content, being greater than the application of chitosan alone, or of some rhizobacteria separately and the control.
Figure 4 shows the effect of 200 ppm of chitosan (in vitro) potato dextrose agar (PDA) of chitosan onplant growth promoting microorganisms A positive effect of chitosan was recorded on Trichoderma lignorum (Fig. 4- Ab) no difference in the growth of T. lignorum in PDA without chitosan (Figure 4- Aa), although there was a difference in sporulation capacity since T. lignorum generated less sporulation with chitosan than in PDA without chitosan. While the addition of chitosan to the PDA for T. harzianum., a higher percentage of inhibition of Fusarium sp, was registered, with maximum growth and sporulation, (Figure 4- Bb) compared to the growth of T. harzianum without chitosan used as a control (Figure 4-Ba). While the addition of chitosan to PDA mix species of the genus Bacilllus Gram positive: B. tequilensis(BIF), B. subtilis(BITV) and B.subtilis (BCC) grow without problem as shown in Figure 4C (Figure 4- Ca) without difference when PDA chitosan was not added (Figure 4- Cb).

Figure 4 Effect of the addition of chitosan on the growth and antagonistic activity of plant growth promoting microorganisms. A) a- growth of Trichoderma lignorum on PDA with chitosan, b- growth of T. lignorum on PDA without chitosan. B) a- Trichoderma harzianum growth and antagonistic activity against Fusarium sp. b- T. harzianum with chitosan in the inhibition of the growth of Fusarium sp. C) a- growth of the species of the sporulated genus Bacillus in PDA with chitosan, 1- Bacillus tequilensis(BIF), 2- B. subtilis(BITV) and 3- B. subtilis (BCC)., b- Growth B. tequilensis(BIF), 2- B. subtilis(BITV) and 3- B. subtilis (BCC) on PDA without chitosan (control).
Effect of chitosan mixed with cell-free extracts as an antibiotic and/or nanoparticles in PDA on the antifungal activity of plant growth promoting microorganisms In this sense, Rodríguez-Romero et al.,44 in vitro in culture medium mixed chitosan with an extract free of Pseudomonas fluorescens cells that inhibited spore germination by 100% and growth of A. alternata compared to the registered when only the fungicide was used in the culture medium. Hernández-Domínguez et al.,78 when combining chitosan with metabolites of Trichoderma parareesei inhibited the growth of Fusarium oxysporum in PDA. Constantini et al.,79 report that the combination of chitosan nanoparticles and a blueberry extract inhibited Colletotrichum fragariae. Sandoval et al.,80 used a chitosan mixed with fatty acids in the control of Botrytis cinerea.
Al To the National Council of Science and Technology (CONACYT) for the financial support granted to carry out postgraduate studies and to the CIC-UMSNH project 2.7 (2022) for the facilities.
The authors declare no conflicts of interest regarding the publication of this paper.

©2022 Gallegos-Morales, et al. This is an open access article distributed under the terms of the, which permits unrestricted use, distribution, and build upon your work non-commercially.